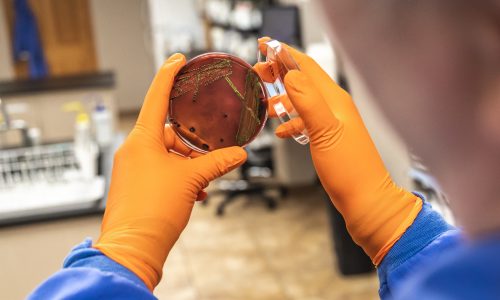
Safe Foods Partners with Category 3 Processing Plant to Address Salmonella Threat

Case Study: How the MARC System Helped Significantly Reduce Water Usage
Industry Challenge: Water Use in Poultry Processing Water is a critical resource in poultry processing, used for cleaning, sanitation, and daily operational needs. From hot water for plant sanitation to...